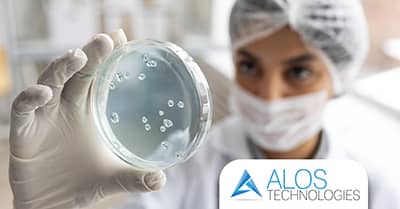
Come proteggere una struttura sanitaria da legionella e contaminazioni dell'acqua

Alos Technologies - ultime notizie
La sezione riporta le novità nei servizi e nelle attività di progettazione, di produzione e di commercializzazione dei dispositivi medici; di apparecchiature per i monitoraggi dei Gas e dell'ambiente. Un canale sempre puntato sulle più recenti scoperte dei sistemi nel settore della sanità, per una migliore informazione e conoscenza di tutti.
- Dettagli
- Scritto da Roberto
La sicurezza dell’acqua è un fattore fondamentale nella gestione delle strutture sanitarie, siano esse pubbliche o private. Ogni giorno, ospedali e cliniche utilizzano grandi quantità di acqua per attività cliniche, terapeutiche, diagnostiche e di servizio. Tuttavia, proprio attraverso le reti idriche può diffondersi uno dei rischi più pericolosi per la salute: la legionella, un batterio capace di provocare gravi infezioni respiratorie.
Contrastare il rischio di diffusione della Legionella e delle contaminazioni richiede strategie mirate e un approccio tecnico altamente specializzato. Per questo motivo, il trattamento dell’acqua rappresenta una delle precauzioni più efficaci per tutelare pazienti e operatori sanitari. Scopri come Alos Technologies protegge la tua struttura sanitaria con soluzioni integrate e certificate per il controllo e la gestione del rischio microbiologico.

- Dettagli
- Scritto da Roberto
Le sale operatorie sono tra gli ambienti più sensibili di una struttura sanitaria, sia pubblica che privata. Igiene, efficienza e sicurezza devono convivere in un equilibrio perfetto. Per questo motivo, l’allestimento di sale operatorie non può essere lasciato al caso: ogni dettaglio, dalla progettazione impiantistica alla scelta delle apparecchiature medicali, deve essere curato a regola d’arte e nel rispetto delle normative vigenti.
Affidarsi a un interlocutore competente, in grado di gestire l’intero processo di realizzazione e gestione, è la scelta migliore da fare. Scopri il servizio di realizzazione di sale operatorie chiavi in mano di Alos Technologies, azienda leader dal 2009 nella progettazione e allestimento di ambienti sanitari ad alta complessità.

- Dettagli
- Scritto da Roberto
La qualità dell’acqua è un fattore primario nella gestione delle strutture sanitarie, siano esse pubbliche o private. Ogni giorno viene impiegata per attività cliniche, terapeutiche, diagnostiche e di servizio, rendendo essenziale garantire i più alti standard di igiene. In questo contesto, il trattamento dell’acqua nelle strutture sanitarie non è solo una necessità tecnica, ma un requisito fondamentale per la sicurezza dei pazienti, degli operatori e degli impianti. Alos Technologies, grazie alla divisione Igiene & Disinfezione, propone un servizio di trattamento dell’acqua completo e personalizzato, in grado di rispondere alle esigenze specifiche di ospedali, cliniche e reparti specialistici.

- Dettagli
- Scritto da Roberto
Garantire la qualità dei gas medicali all’interno delle strutture sanitarie è una priorità assoluta per la sicurezza dei pazienti e per l’operatività del personale medico. Gli impianti di gas medicali, infatti, sono complessi sistemi di distribuzione che richiedono progettazione accurata, gestione attenta e manutenzione costante per ridurre al minimo i rischi di malfunzionamenti. Dal 2009, Alos Technologies è specializzata nella progettazione, realizzazione e commercializzazione di impianti gas medicali certificati, offrendo alle strutture sanitarie pubbliche e private soluzioni integrate e servizi innovativi.

- Dettagli
- Scritto da Roberto
Le sale operatorie sono tra le aree più sensibili e complesse all’interno di una struttura sanitaria, poiché da esse dipendono la sicurezza dei pazienti e l’efficacia degli interventi chirurgici. Per il loro allestimento è indispensabile affidarsi a professionisti del settore, in grado di fornire soluzioni integrate e tecnologicamente avanzate. Dal 2009, Alos Technologies è partner di riferimento per ospedali e cliniche pubbliche e private, offrendo un servizio full-service che accompagna il cliente in tutte le fasi: dalla progettazione all’assistenza post-vendita. Scopri di più in questo articolo.

- Dettagli
- Scritto da Roberto
La qualità di una struttura sanitaria dipende non solo dalla competenza del personale e dalla tecnologia delle apparecchiature, ma anche dall’efficienza degli impianti che la rendono operativa. La progettazione degli impianti delle strutture sanitarie, sia pubbliche che private, rappresenta infatti uno dei pilastri fondamentali per garantire sicurezza, continuità dei servizi e conformità normativa. Ogni reparto, ogni sala operatoria, ogni laboratorio ha esigenze specifiche che devono essere considerate già nelle fasi iniziali della progettazione per assicurare ambienti sicuri, affidabili e a norma.
